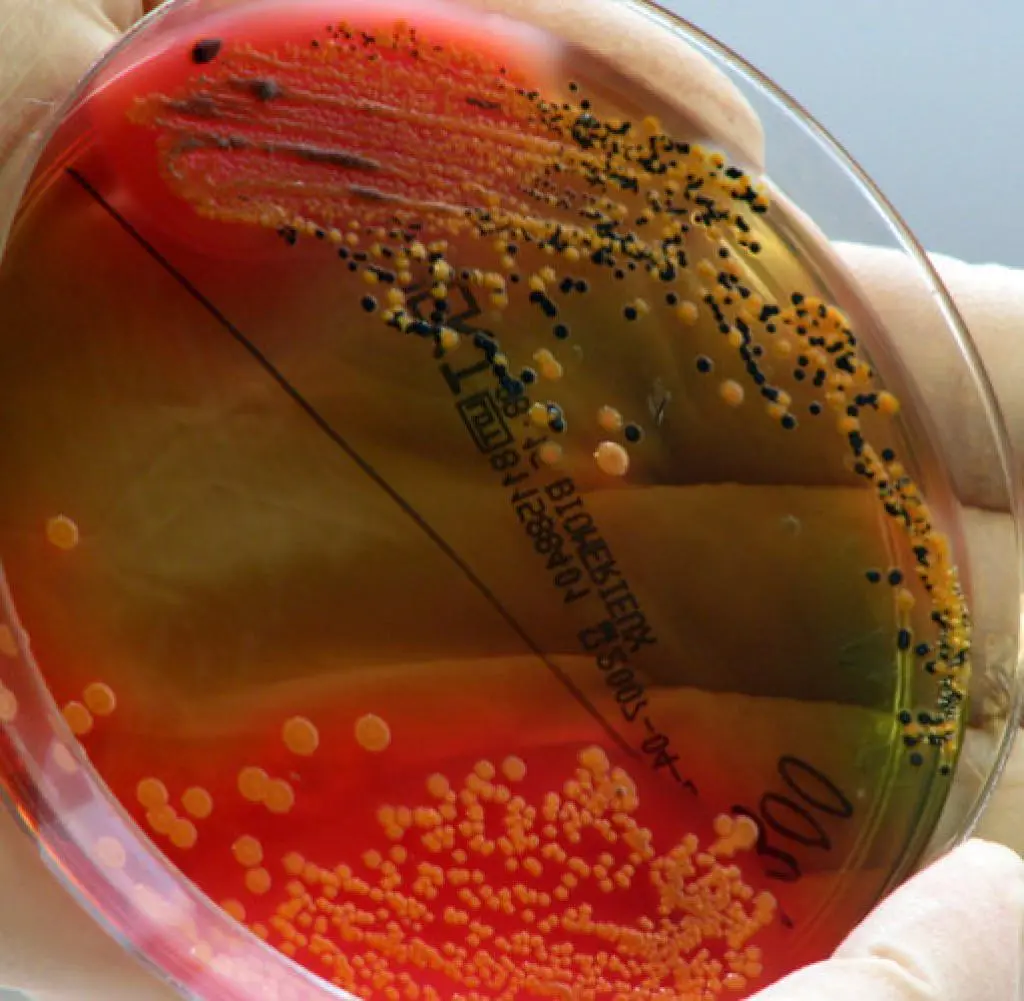

Salmonellen sind Bakterien, die Lebensmittelvergiftung verursachen können. Sie können in verschiedenen Lebensmitteln vorkommen, darunter Eier, Geflügel, rohes Fleisch und Milchprodukte. Salmonellen können bei Raumtemperatur mehrere Stunden überleben, aber sie werden bei hohen Temperaturen abgetötet. Um das Risiko einer Salmonellenvergiftung zu minimieren, ist es wichtig, Lebensmittel richtig zu lagern und zu kochen.
Wie lange überleben Salmonellen in Eiern?
Salmonellen können in rohen Eiern vorkommen und können beim Verzehr von rohen oder unzureichend gegarten Eiern Krankheiten verursachen. Salmonellen können in Eiern überleben, bis sie gekocht werden. Die Hitze beim Kochen tötet die Salmonellen ab.
Die Temperatur, bei der Salmonellen absterben, hängt von verschiedenen Faktoren ab, darunter die Art der Lebensmittel und die Zeit, die sie erhitzt werden. Im Allgemeinen werden Salmonellen bei einer Temperatur von 74 °C (165 °F) für mindestens 2 Minuten abgetötet.
Wie lange können Salmonellen auf Flächen überleben?
Salmonellen können auf Flächen wie Arbeitsplatten, Schneidebrettern und Besteck überleben. Sie können auch auf Oberflächen wie Handtüchern und Kleidung überleben. Salmonellen können auf Oberflächen für mehrere Stunden oder sogar Tage überleben, abhängig von der Temperatur und der Feuchtigkeit.
Um das Risiko einer Salmonellenvergiftung zu minimieren, ist es wichtig, alle Oberflächen, die mit rohem Fleisch, Geflügel oder Eiern in Kontakt gekommen sind, gründlich zu reinigen. Verwenden Sie warmes Seifenwasser und desinfizieren Sie die Oberflächen nach dem Reinigen.
Wie kann ich Salmonellen in Lebensmitteln vermeiden?
Es gibt verschiedene Maßnahmen, die Sie ergreifen können, um das Risiko einer Salmonellenvergiftung zu minimieren:
- Waschen Sie Ihre Hände gründlich mit Seife und Wasser, bevor Sie Lebensmittel zubereiten und nach dem Umgang mit rohem Fleisch, Geflügel oder Eiern.
- Waschen Sie Obst und Gemüse gründlich mit kaltem Wasser, bevor Sie es essen.
- Kochen Sie Fleisch, Geflügel und Eier gründlich durch. Die Temperatur im Inneren sollte mindestens 74 °C (165 °F) betragen.
- Lagern Sie rohe Fleisch-, Geflügel- und Eierprodukte getrennt von anderen Lebensmitteln im Kühlschrank.
- Verwenden Sie separate Schneidebretter für rohes Fleisch, Geflügel und Eier.
- Verwenden Sie keine bereits abgelaufenen Lebensmittel.
Symptome einer Salmonellenvergiftung
Die Symptome einer Salmonellenvergiftung treten normalerweise 12 bis 72 Stunden nach dem Verzehr von kontaminierten Lebensmitteln auf. Zu den Symptomen können gehören:
- Durchfall
- Fieber
- Bauchkrämpfe
- Übelkeit
- Erbrechen
- Kopfschmerzen
Die meisten Menschen erholen sich von einer Salmonellenvergiftung innerhalb weniger Tage. Wenn Sie jedoch schwere Symptome haben, sollten Sie einen Arzt aufsuchen.
Wie lange sind Salmonellen in Eiern lebensfähig?
Salmonellen können in Eiern bei Raumtemperatur mehrere Stunden überleben. Sie werden jedoch bei hohen Temperaturen abgetötet. Die Temperatur, bei der Salmonellen in Eiern absterben, beträgt 74 °C (165 °F) für mindestens 2 Minuten.

Können Salmonellen in Eiern durch Kochen abgetötet werden?
Ja, Salmonellen in Eiern können durch Kochen abgetötet werden. Die Hitze beim Kochen tötet die Salmonellen ab. Es ist wichtig, Eier gründlich zu kochen, um sicherzustellen, dass die Innentemperatur mindestens 74 °C (165 °F) erreicht.
Kann man rohe Eier essen, ohne krank zu werden?
Es ist nicht empfehlenswert, rohe Eier zu essen, da sie Salmonellen enthalten können. Die meisten Menschen erholen sich von einer Salmonellenvergiftung innerhalb weniger Tage. Wenn Sie jedoch schwere Symptome haben, sollten Sie einen Arzt aufsuchen.

Wie kann ich verhindern, dass Salmonellen auf Flächen überleben?
Um das Risiko einer Salmonellenvergiftung zu minimieren, ist es wichtig, alle Oberflächen, die mit rohem Fleisch, Geflügel oder Eiern in Kontakt gekommen sind, gründlich zu reinigen. Verwenden Sie warmes Seifenwasser und desinfizieren Sie die Oberflächen nach dem Reinigen.
Zusammenfassung
Salmonellen sind Bakterien, die Lebensmittelvergiftung verursachen können. Sie können in verschiedenen Lebensmitteln vorkommen, darunter Eier, Geflügel, rohes Fleisch und Milchprodukte. Salmonellen können bei Raumtemperatur mehrere Stunden überleben, aber sie werden bei hohen Temperaturen abgetötet. Um das Risiko einer Salmonellenvergiftung zu minimieren, ist es wichtig, Lebensmittel richtig zu lagern und zu kochen.
Wenn Sie rohe Eier essen, sollten Sie diese gründlich kochen, um sicherzustellen, dass die Innentemperatur mindestens 74 °C (165 °F) erreicht. Wenn Sie rohes Fleisch, Geflügel oder Eier zubereiten, sollten Sie alle Oberflächen gründlich mit warmem Seifenwasser reinigen und desinfizieren.
Wenn Sie Symptome einer Salmonellenvergiftung haben, sollten Sie einen Arzt aufsuchen.
Wenn Sie andere Artikel kennenlernen möchten, die Wann sterben Salmonellen in Lebensmitteln ab? ähneln, können Sie die Kategorie Lebensmittelhygiene besuchen.